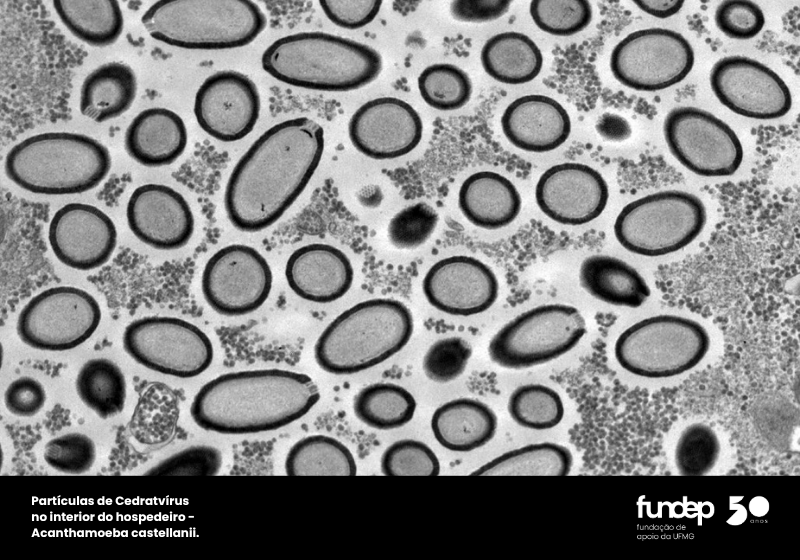

02

03

04

05

06

07

08

09

10

11

12

13

14

15

16

17

18

19

20
21

22

23

24

25

O Centro de Microscopia da UFMG é uma instalação científica com infraestrutura projetada para eliminar vibrações e garantir controle térmico, essenciais para microscopia de alta resolução.
A Fundep foi parceira fundamental desde a concepção do projeto, viabilizando a construção e a aquisição de equipamentos de alto custo. Por mais de duas décadas, a Fundação mantém o apoio contínuo na gestão de recursos e na manutenção tecnológica do Centro.
Essa colaboração permitiu que o Centro se tornasse um recurso vital, atendendo a diversas áreas de pesquisa e contribuindo para descobertas científicas de impacto internacional.


